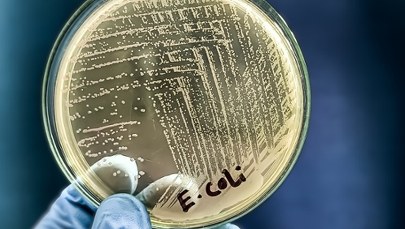
​Sześć miejscowości bez wody. To kolejny taki przypadek na Dolnym Śląsku

"Model ekonomiczny Polski się zmienił" - mówił w Popołudniowej rozmowie w RMF FM wiceminister aktywów państwowych Konrad Gołota. Przedstawiciel rządu poinformował, że Polska stawia na wymianę technologii wojskowej z innymi krajami i rozwijanie własnych możliwości produkcyjnych. Tematem dzisiejszej rozmowy była przyszłość polskiej zbrojeniówki.
- Po więcej aktualnych informacji zapraszamy na RMF24.pl
Kiedy Polska będzie kupować sprzęt w Polsce, a nie za granicą? Prace trwają.
Prowadzimy wieluset milionowe inwestycje. Bumar Łabędy, to jest linia tworzona po to, byśmy mogli tam wymiennie produkować albo Kraby (polskie armatohaubice - red.), albo czołgi, albo pojazdy opancerzone - mówi Gołota.
Jak wyjaśnia, stworzenie takiej linii produkcyjnej, to proces, który w przyspieszonym tempie zajmuje od 2 do 3 lat. Szybciej się nie da - ocenia wiceminister, tłumacząc, że czas oczekiwania wydłuża się np. ze względu na dostawy specjalistycznych maszyn do produkcji sprzętu wojskowego.
Rząd PiS zapowiadał zwiększenie produkcji amunicji 155 mm. Zero inwestycji. Nie było żadnych projektów inwestycyjnych - mówi Gołota. W latach 2016-2022 nasza produkcja wynosiła średnio 5 tys. sztuk (amunicji) rocznie. My budujemy trzy fabryki amunicji, które mają osiągać 150-180 tys. sztuk amunicji rocznie - dodaje, wyjaśniając, że Polska musiała pozyskać specjalne technologie, by otworzyć linie. Według deklaracji wiceministra za 2-3 lata będziemy produkować amunicję od A do Z w Polsce.
Konrad Gołota został zapytany, czy rozbudowa mocy zbrojeniowych będzie finansowana z unijnego programu SAFE?
Wiceszef MAP podkreślił, że obecne przepisy ograniczają wykorzystanie środków z Funduszu Wsparcia Sił Zbrojnych.
Dzisiaj nasze uwarunkowania legislacyjne nie pozwalają na to, żeby z pieniędzy, które trafią do Funduszu Wsparcia Sił Zbrojnych, można było wydawać pieniądze na cokolwiek innego niż na zakup - wyjaśnił wiceminister.
To w skrócie może oznaczać, że będziemy wspierali rozwój przemysłu zbrojeniowego w Europie - w Niemczech, we Francji i Szwecji - dodał.
Dlatego - jak tłumaczył - rząd pracuje nad nowym instrumentem finansowym, który pozwoli na rozwój polskiego przemysłu zbrojeniowego.
Jesteśmy w bardzo zaawansowanych pracach z Ministerstwem Finansów i Ministerstwem Obrony Narodowej nad instrumentem, który pozwoli nam lokować pieniądze w rozwój naszego przemysłu obronnego - podkreślił.
Wiceminister ujawnił, że jednym z rozważanych rozwiązań jest stworzenie funduszu podobnego do Funduszu Inwestycji Kapitałowych.
Jedną z koncepcji jest stworzenie podobnie działającego funduszu, na który zostanie przekierowana część pieniędzy z SAF-u i który będzie mógł wesprzeć rozwój naszego przemysłu obronnego. Musimy to zrobić - powiedział Gołota.
To nie jest dotacja wprost, tylko objęcie dodatkowego pakietu udziałów przez ministra aktywów państwowych - dodał, wyjaśniając mechanizm działania.
Zgodnie z wizją wiceministra Polska musi przestawiać się na suwerenną produkcję, tak by w momencie kryzysowym utrzymać stałe dostawy sprzętu dla wojska. To oczywiście nie wyklucza współpracy z podmiotami z innych krajów Europy. Najlepszym przykładem są ostatnie rozmowy ze Szwecją, które mogą - zdaniem wiceministra - dać podwaliny pod coś, co można będzie nazwać "game changerem".
W grę wchodzi współpraca przy produkcji rakiet, systemów antydronowych i do walki elektronicznej - wyliczał Gołota, dodając: rozmawiamy ze Szwedami o transferze technologii.
Wiceminister przekazał, że obecnie opracowywany jest ciężki wóz bojowy piechoty. W przyszłym roku ma pojawić się gotowy prototyp.
Dla mnie ważna jest suwerenność przemysłowa. Jeśli coś się stanie, jesteśmy niezależni - podkreśla.
Korzystamy jednak także z produkcji zagranicznej.
Polska - jak ujawnił Gołota - kontynuuje rozmowy z partnerami z Korei Południowej dotyczące produkcji i transferu technologii czołgów K2 "Pantera".
Odbyłem ostatnio dwie wizyty w Korei. Mam wrażenie, że z każdym tygodniem coraz lepiej rozumieją, że Polska nie jest już tylko klientem, ale partnerem - powiedział wiceszef MAP.
Na umowy czekam. Mam nadzieję, że w październiku lub listopadzie będziemy mogli o nich powiedzieć więcej - dodał.
Według Gołoty, umowa ramowa dotyczy ponad tysiąca czołgów K2, a zainteresowanie "spolonizowanymi" czołgami wykazują już inne kraje - m.in. Rumunia i Słowacja.
Zdaniem Konrada Gołoty ważne jest rozwijanie wspólnego przemysłu zbrojeniowego w Europie, a nie indywidualnie w poszczególnych krajach.
Chcę żeby PGZ (Polska Grupa Zbrojeniowa - red.) był integratorem całego przemysłu zbrojeniowego w Polsce. Jest cała masa prywatnych firm, które mają ciekawe rozwiązania - mówi wiceminister.
Podkreśla także, iż warunki, w których funkcjonuje polski przemysł zmieniły się i ta nowa rzeczywistość determinuje charakter relacji z zagranicznymi partnerami. Model ekonomiczny Polski się zmienił. Zapraszamy do współpracy i transferu technologii. Albo ktoś przychodzi do nas z partnerstwem na dekady albo nie jesteśmy zainteresowani - podkreśla.
Na pytanie Marka Tejchmana o wpływ związków zawodowych w państwowych spółkach zbrojeniowych Gołota odpowiedział bez wahania: Trzy lub czterokrotnie spotykałem się ze związkami zawodowymi. Nie mamy konfliktów, prowadzimy dialog - powiedział wiceminsiter.
Odnosząc się do listu Krajowej Sekcji Przemysłu Zbrojeniowego NSZZ "Solidarność", w którym związkowcy krytykują rząd za współpracę z prywatnymi firmami, Gołota zaznaczył, że państwowy przemysł ma być liderem i integratorem całego sektora.
Państwowy przemysł obronny daje platformy, gdzie rozwiązania małych, prywatnych firm mogą zaistnieć. Tak, jak przy projekcie Borsuka - tam też są rozwiązania prywatnych spółek - wyjaśnił.
Wiceminister przestrzega też przed zbyt szybkim rozwojem państwowych zakładów zbrojeniowych.
Nie możemy przegrzać i przeskalować tego przemysłu. Dzisiaj związkowcy chcą, by wszystko było lokowane u nas, ale kiedyś te zamówienia się skończą - powiedział polityk Lewicy.
Jak zaznaczył wiceminister, przemysł zbrojeniowy nie będzie dotować bezpośrednio Jastrzębskiej Spółki Węglowej.
Nie chciałbym wchodzić w kompetencje mojego kolegi, ministra Grzegorza Wrony. Ale będziemy szukać synergii w ramach spółek Skarbu Państwa - powiedział.
Polski przemysł obronny nie ma planów bezpośredniego zaangażowania finansowego w JSW, ale pośrednio - poprzez zakupy stali - oczywiście tak - dodał.
Zachęcamy do subskrybowania naszego kanału na YouTube https://www.youtube.com/@RMF24Video.